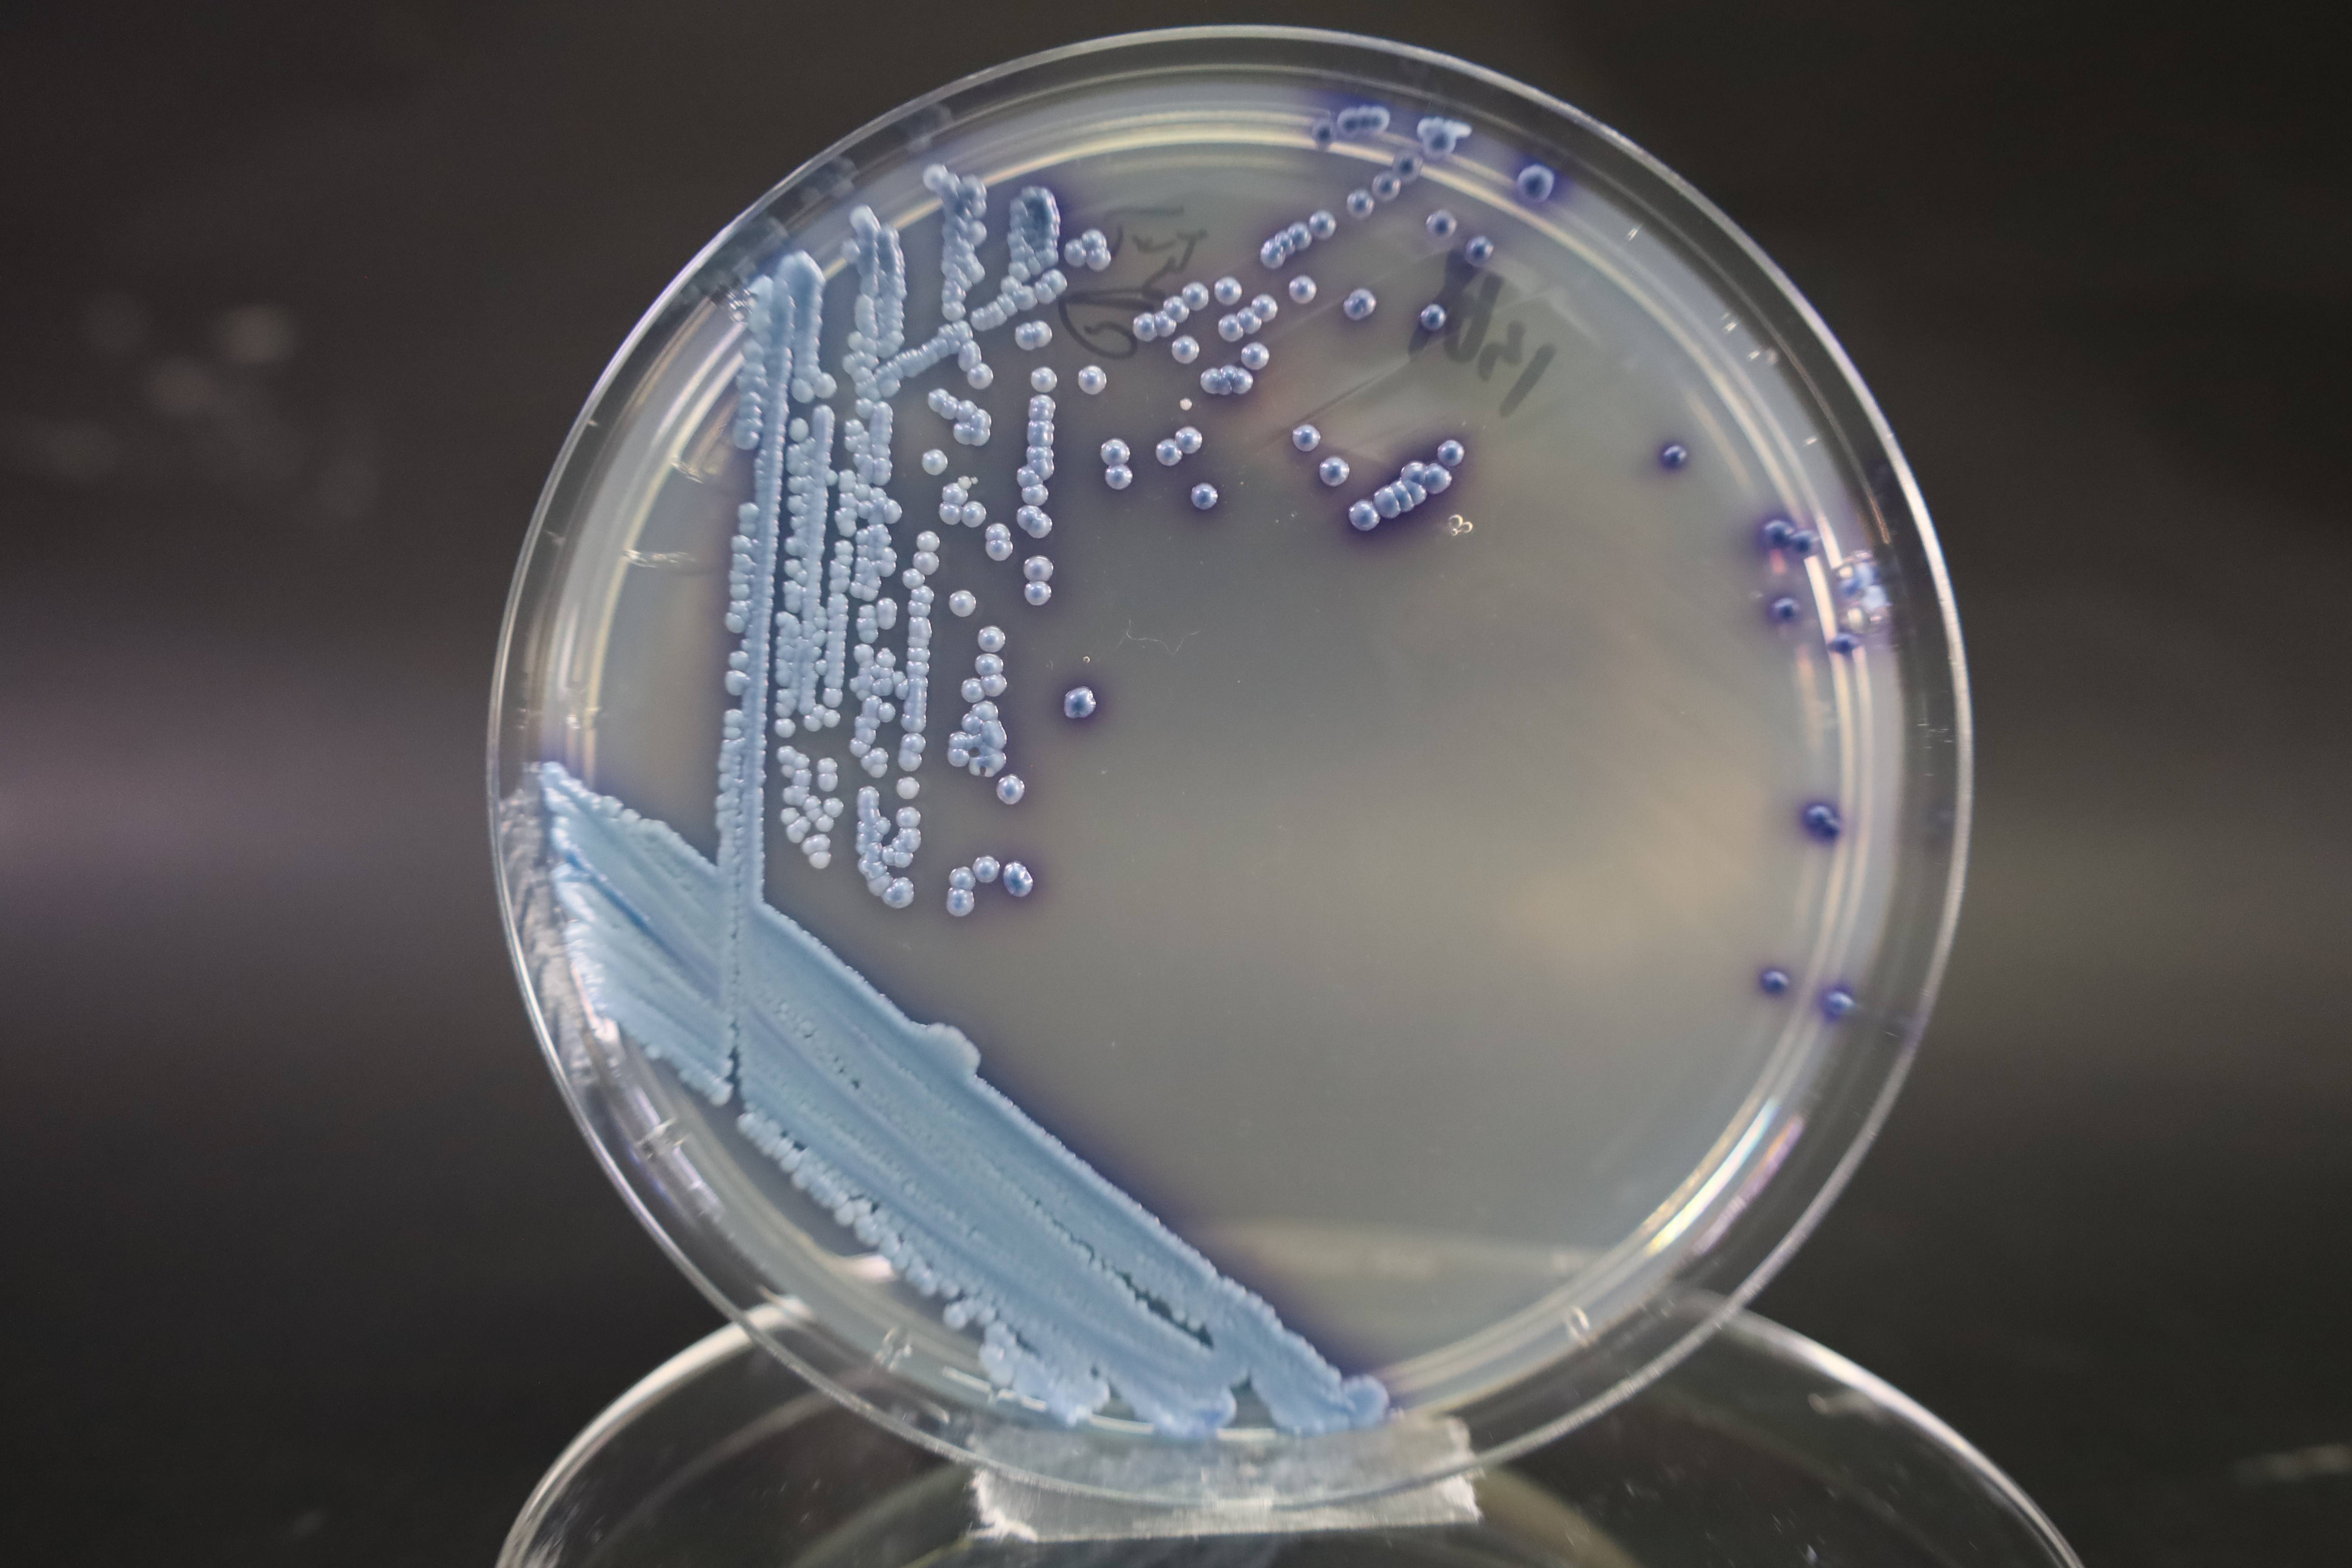

微生物培养基中的生长因子指哪些,微生物培养基的碳源氮源无机盐生长因子有哪些
发布时间:2023-11-10 浏览次数:4664
微生物培养基(Microbial culture medium)是人工配制的适合微生物生长繁殖或积累代谢产物的营养基质。任何培养基中均需含有微生物所必需的能源、碳源、氮源、矿质元素、水和生长因素,但不同营养类型、不同种类的微生物对营养元素的要求又有很大差异。目前已使用的各种培养基都是前人经过反覆实践,比较设计的成果。
培养基的基本成分
能源、碳源:自养微生物以二氧化碳为碳源,光或无机物为能源,在无机物组成的培养基中生长。例如化能自养型的氧化硫杆菌培养基中,加入粉末状硫为能源,以空气中的CO2为碳源。
异养微生物以有机物为碳源和能源,培养基中常需加入葡萄糖、蔗糖或麦芽糖、乳糖等单糖或双糖,有的可利用淀粉、纤维素等多糖,或利用动物组织中的糖类。例如培养细菌常用的牛肉膏蛋白胨培养基,其中牛肉膏即为主要碳源和能源。
氮源:自养微生物以含氮无机物铵盐、硝酸盐等为氮素营养,例如氧化硫杆菌以(NH4)2SO4为氮源;异养微生物以无机物铵盐、硝酸盐或含氮有机物为氮源。自生固氮菌利用空气中的N2为氮素营养,其培养基中无须加入氮源,称为无氮培养基。
矿质元素、生长因子:微生物生长繁殖需要P、K、Na、S、Mg、Ca等主要矿质元素以及Fe、Cu等微量元素,因此培养基中常加入K2HPO4、KH2PO4、MgSO4、NaCl、KCl、FeSO4等无机盐类;生长因子主要是调节微生物代谢活动的B族维生素,常由酵母膏、肝浸出液等提供。许多天然成分的原料如牛肉膏、麦芽汁、玉米粉、豆芽汁等,含有各种无机元素和生长因子,不需另外添加。

培养基的类型 根据原料来源不同,可将培养基分为合成培养基、半合成培养基与天然培养基。
合成培养基:由化学成分已知的有机物和无机物配制而成。成分精确,重复性强。
但营养侷限,微生物生长缓慢。适用于菌种分离、选育、遗传分析及生物测定等。如培养放线菌的高氏培养基、培养霉菌的察氏培养基以及各种化能自养菌培养基等。
半合成培养基:由某些天然物质与少量已知成分的化学物质配制而成。营养全面,能有效地满足微生物对营养的需求。
广泛应用于微生物的培养。如培养细菌用的牛肉膏蛋白胨培养基,培养霉菌的土豆葡萄糖培养基,工业生产中常用的玉米粉等天然物质加无机盐配制的各种发酵培养基等。
天然培养基:由化学成分不清楚或不衡定的天然有机物配制而成。成分复杂,但营养丰富全面。常用于实验研究和生产。如麦芽汁培养基、玉米粉培养基,以及生产中使用的麸皮、锯末等。
根据培养基的物理性质,可分为液体培养基、固体培养基和半固体培养基。
液体培养基:用各种营养成分加水配成,或用天然物质的浸汁(麦芽汁、豆芽汁等)制成。组分均一,适宜各类微生物的营养生长。
广泛应用于实验研究及大规模工业生产中,有利于广泛获得大量菌体或代谢产物。
固体培养基:在液体培养基中加入凝固剂,或用麸皮等固体原料配制。常用的凝固剂是琼脂(又称琼胶、洋菜),由石花菜等海藻中提取加工制成。
市售琼脂为条状、片状或粉末状,主要成分为多聚半乳糖的硫酸酯,绝大多数微生物不能将其分解,在培养基中仅起支撑作用。其熔点约98℃,凝固点42℃,1.5~2%的水溶液在一般培养温度下呈凝胶状态。
琼脂固体培养基广泛应用于微生物的分离培养、菌种鉴定和保藏。
半固体培养基:液体培养基中加入0.2~0.5%琼脂制成。用于观察细菌的运动、菌种鉴定及测定噬菌体的效价等。
根据培养基的用途,可分为选择培养基、鉴别培养基、加富培养基、基本培养基等。
选择培养基:根据某一类或某种微生物的特殊营养要求而设计的培养基,用于提高所需微生物的分离效率。如分离固氮微生物的无氮培养基、加入滤纸条或纤维素粉为碳源分离纤维分解菌的培养基。
在培养基中加入某种化合物,可有效地分离出对这种化合物有抗性的微生物,例如在放线菌培养基中加入数滴10%的酚,可抑制细菌和霉菌的生长;加入一定量的青霉素、链霉素,可抑制细菌生长等。
鉴别培养基:根据微生物的代谢特点,在培养基中加入某种指示剂,通过显色反应以鉴别不同的微生物。例如检查乳制品和饮用水中是否有肠道细菌污染所用的伊红-美蓝培养基。
当大肠杆菌等肠道细菌生长时,发酵培养基中的乳糖,使加入的伊红-美蓝变色,在菌落上沉积为紫黑色,并呈现金属光泽。

培养基的制备方法 以下为常规方法,如配方中有特殊规定或要求,以配方为依据。
1,根据配方,计算各种营养成分用量。一般药品可用普通药物天平称量,用量少的药品,可按比例配成高浓度溶液,再按所需量用移液管吸取。称好的药品放入玻璃烧杯或搪瓷杯中。
2,在另一容器中将所需量的水(一般可用自来水,有特殊要求时需用蒸馏水)加热,取全量的1/3左右倒入放药品的容器中,用玻璃棒搅拌,待药品全溶后,再将其余热水全部倒入。
3,若配制固体培养基,则称取1.5~2%的琼脂放入已溶化的营养液中,继续加热至琼脂全部溶解。
加热中随时搅拌,防止溢出或糊底。烧糊的培养基营养物质破坏,并产生有毒物质,不宜再用。
4,待溶化的培养基稍冷却后,按配方要求调整pH值。先取10毫升培养基装入试管中,用pH试纸测其自然pH,再用1%NaOH(或1%HCl)调至所需pH,根据用量计算,换用10%NaOH(或10%HCl)调整所配全量培养基的pH。
加硷(或酸)溶液时,应边滴加边搅拌,至应加量将近用完时,再次测试,最后调至要求的pH值。
5,配好的培养基,根据需要趁热分装至试管或锥形瓶中。分装需用漏斗,以免琼脂粘在管口或瓶口上。
装瓶量一般为瓶容量的1/3~1/2;装试管一般为试管高度的1/5~1/4,以免灭菌时培养基上溢,粘溼棉塞。
6,用预先制好的棉塞塞住管口或瓶口。棉塞既有利于通气,又有滤菌作用,故松紧、大小应适当,以免使用时影响操作(如图)。
最后用牛皮纸或报纸包住棉塞,扎紧在瓶颈或试管上方,以免灭菌时水蒸汽沾溼棉塞或脱落。
7,灭菌后取出的固体培养基,根据需要可将试管立即斜放,冷凝后即成斜面培养基,用于菌种扩大培养及保藏;锥形瓶中的培养基,倒入无菌培养皿中,冷凝后即制成平板培养基,可用于菌种的分离、鉴定等。液体培养基冷却后可直接根据需要接入菌种。
